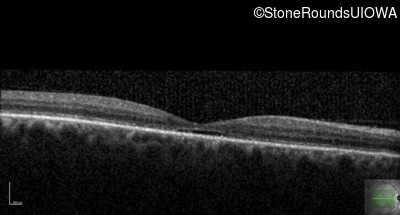
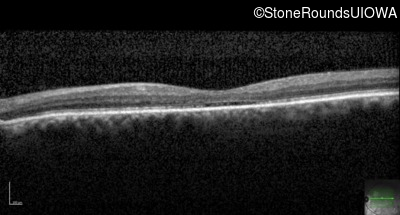

Case
SR694
Student Mode
Blue Cone Monochromacy (IA2e)
Male
Male
Hidden
SR694
Student Mode
Blue Cone Monochromacy (IA2e)
Male
Male
History
This 65 year old man has had nystagmus since birth. His acuity was never better than 20/80 in either eye. He has significant photophobia in normal office light but sees normally in very dim light. His color vision is also poor. He cannot recognize any of the Ishihara color plates.
Diagnosis & molecular findings
| Disease | Gene | Allele 1 variant(s) | Allele 2 variant(s) | Inheritance mode |
|---|---|---|---|---|
| Blue Cone Monochromacy | L/M OPSIN Cluster | Promoter Deletion LCR | XL |
Disease:
Gene:
Allele 1:
Promoter Deletion LCR
Allele 2:
Inheritance:
XL